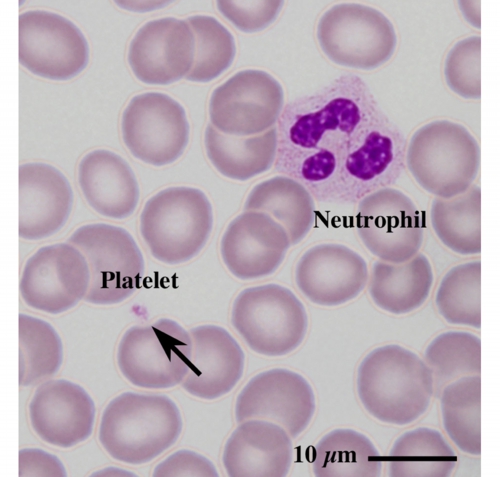

血小板(ヒト) Platelets ( human )
末梢血塗末標本のギムザ染色光学顕微鏡画像
Light microscopic image of peripheral blood smear with Giemsa staining
止血などに関わる血小板の直径は僅か2 µmしかなく、
詳細な観察には高い解像度を有する電子顕微鏡が必要です。
ヒト血小板(矢印)
(末梢血塗末標本のギムザ染色光顕像)
【 薄さ70 - 80 nm 超薄切片の透過型電子顕微鏡画像 】
Transmission electron microscopic image of 70 - 80 nm ultrathin section
